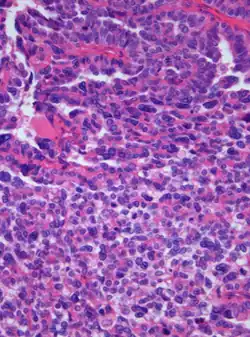

Plexuskarzinom
| Klassifikation nach ICD-10 | |
|---|---|
| C71.5 | Bösartige Neubildung des Hirnventrikels |
| ICD-10 online (WHO-Version 2019) | |
Das Plexuskarzinom ist ein bösartiger Hirntumor, der wahrscheinlich vom Epithel des Plexus choroideus ausgeht, daher auch die Bezeichnung Plexus-choroideus-Karzinom. Es wird nach der WHO-Klassifikation der Tumoren des zentralen Nervensystems als Grad III eingeteilt und macht weniger als 0,4 % aller Hirntumoren aus. Ganz überwiegend sind Kinder und Jugendliche betroffen; im ersten Lebensjahr gehören Plexuskarzinome mit zu den häufigsten Hirntumoren.[1] Meist handelt es sich um sporadische Fälle, bei denen kein Zusammenhang mit einer erblichen Erkrankung erkennbar ist. Beim Li-Fraumeni-Syndrom treten Plexuskarzinome gehäuft auf. Ein gutartiger Tumor des Plexus choroideus wird als Plexuspapillom bezeichnet.
Symptome
Aufgrund ihrer Lage innerhalb des Ventrikelsystems behindern Plexuskarzinome häufig den Fluss des Hirnwassers, was zu einer Erhöhung des Hirndrucks führen kann. Kopfschmerz, Übelkeit und Erbrechen sind typische aber unspezifische Symptome. In fortgeschrittenen Fällen kann es zur Entwicklung eines Hydrozephalus (Wasserkopf) kommen.[2]
Pathologie
Hämatoxylin-Eosin gefärbtes Schnittpräparat. Originalvergrößerung 1:400
Das histologische Bild ähnelt nur noch entfernt dem des normalen Plexus choroideus: Das bei den gutartigen Plexuspapillomen noch deutlich erkennbare papilläre Wachstumsmuster ist größtenteils aufgehoben, mitotische Aktivität, Zelldichte und Zellkernpolymorphie (Vielgestaltigkeit) sind erhöht. Häufig treten auch Tumornekrosen auf oder es kommt zu einer diffusen Infiltration des Gehirns. Schwierigkeiten kann bei Erwachsenen die diagnostische Abgrenzung gegenüber Karzinommetastasen bereiten, da sich das immunhistochemische Expressionsprofil konventioneller diagnostischer Marker überlappt. Der immunhistochemische Nachweis einer Expression des Aminosäuretransporters Excitatory Amino Acid Transporter-1 sowie des einwärts gleichrichtenden Kaliumkanals Kir7.1 kann die Verdachtsdiagnose eines Plexuskarzinoms erhärten.[3][4]
Pathogenese
Über an der Pathogenese von sporadischen Plexuskarzinomen beteiligte Faktoren ist nur wenig bekannt. Zwar sind Mutationen des SMARCB1-Gens (INI1), die typischerweise bei atypischen teratoiden/rhabdoiden Tumoren (WHO Grad IV) vorkommen, auch in Plexuskarzinomen beschrieben worden, offenbar hat es sich hierbei jedoch in der Mehrzahl der Fälle rückblickend um fehldiagnostizierte atypische teratoide/rhabdoide Tumoren gehandelt.[5]
Therapie
Die vollständige operative Entfernung kann sich durch das infiltrative Wachstum und den Blutgefäßreichtum von Plexuskarzinomen schwierig gestalten. Im Rahmen der weiteren Behandlung, die obligatorisch im Rahmen klinischer Studien erfolgt, schließt sich deswegen üblicherweise eine begleitende Chemotherapie an.[6] Eine internationale Therapiestudie, die unter der Schirmherrschaft der Internationalen Gesellschaft für Pädiatrische Onkologie (SIOP) durchgeführt wird, ist die CPT-SIOP-2000-Studie. Auch einer Strahlentherapie des Tumors kann im Rahmen eines individuellen Therapiekonzepts eine Rolle zukommen.[7]
Prognose
Auch nach vollständiger operativer Entfernung ist der weitere Verlauf von Plexuskarzinomen von häufigen Rezidiven geprägt.[8]
Veterinärmedizin
Selten kommen Plexuskarzinome auch bei Hornträgern vor.[9]
Literatur
- A. Aguzzi, S. Brandner, W. Paulus: Choroid plexus tumours. In: P. Kleihues, W. K. Cavenee (Hrsg.): World Health Organization classification of tumors. Pathology and genetics of tumours of the nervous system. IARC Press, Lyon 2000.
Einzelnachweise
- ↑ C. H. Rickert, W. Paulus: Tumors of the choroid plexus. In: Microsc Res Tech. 2001;52, S. 104–111; PMID 11135453 (Übersichtsarbeit)
- ↑ A. W. McEvoy et al.: Management of choroid plexus tumours in children: 20 years experience at a single neurosurgical centre. In: Pediatr Neurosurg. 2000 Apr;32(4), S. 192–199. PMID 10940770
- ↑ R. Beschorner et al.: Choroid plexus tumors differ from metastatic carcinomas by expression of the excitatory amino acid transporter-1. In: Hum Pathol. 2006 Jul;37(7), S. 854–860. PMID 16784985
- ↑ M. Hasselblatt et al.: Identification of novel diagnostic markers for choroid plexus tumors: a microarray-based approach In: Am J Surg Pathol. 2006;30, S. 66–74. PMID 16330944
- ↑ A. R. Judkins et al.: INI1 protein expression distinguishes atypical teratoid/rhabdoid tumor from choroid plexus carcinoma. In: J Neuropathol Exp Neurol. 2005 May;64(5), S. 391–397. PMID 15892296.
- ↑ B. Wrede et al.: Chemotherapy improves the survival of patients with choroid plexus carcinoma: a meta-analysis of individual cases with choroid plexus tumors. In: J Neurooncol. 2007;85(3), S. 345–351. PMID 17576522
- ↑ J. A. Wolff et al.: Radiation therapy and survival in choroid plexus carcinoma. In: The Lancet. 1999 Jun 19;353(9170), S. 2126. PMID 10382700.
- ↑ J. E. Wolff: Choroid plexus tumours. In: Br J Cancer. 2002 Nov 4;87(10), S. 1086–1091. PMID 12402146 (Meta-Analyse)
- ↑ R. Klopfleisch et al.: Choroid plexus carcinoma in a goat. In: J Comp Pathol. 2006 Jul;135(1), S. 42–46. PMID 16820166